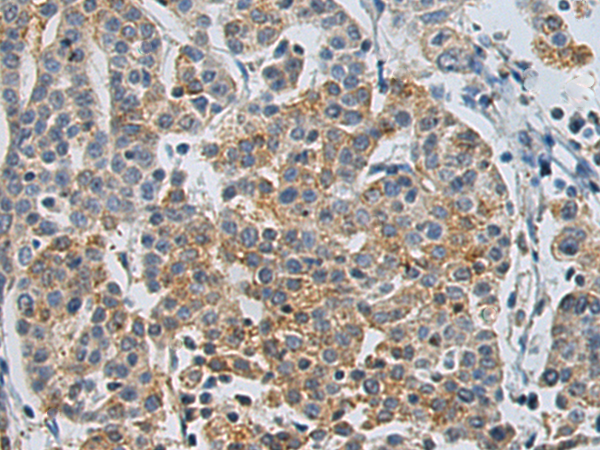

中文名稱:兔抗CLEC14A多克隆抗體
|
Background: |
This gene encodes a member of the C-type lectin/C-type lectin-like domain (CTL/CTLD) superfamily. Members of this family share a common protein fold and have diverse functions, such as cell adhesion, cell-cell signalling, glycoprotein turnover, and roles in inflammation and immune response. This family member plays a role in cell-cell adhesion and angiogenesis. It functions in filopodia formation, cell migration and tube formation. Due to its presence at higher levels in tumor endothelium than in normal tissue endothelium, it is considered to be a candidate for tumor vascular targeting. |
|
Applications: |
ELISA, IHC |
|
Name of antibody: |
CLEC14A |
|
Immunogen: |
Synthetic peptide of human CLEC14A |
|
Full name: |
C-type lectin domain containing 14A |
|
Synonyms: |
CEG1; EGFR-5; C14orf27 |
|
SwissProt: |
Q86T13 |
|
ELISA Recommended dilution: |
5000-10000 |
|
IHC positive control: |
Human cervical cancer |
|
IHC Recommend dilution: |
50-100 |
購物車
購物車 幫助
幫助
 021-54845833/15800441009
021-54845833/15800441009
